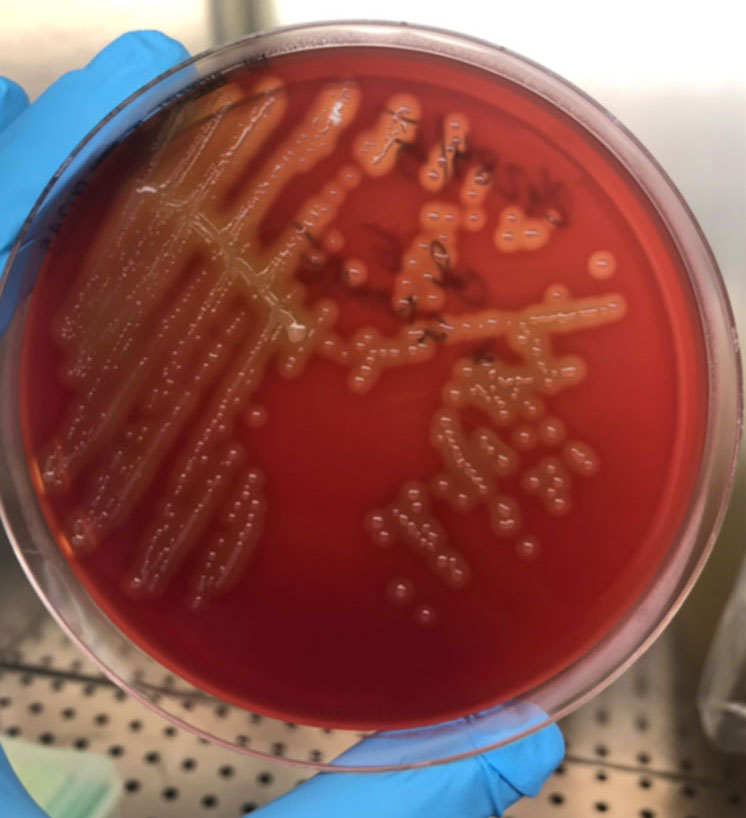

Descrizione di un focolaio epidemico di malattia a trasmissione alimentare causata da Streptococcus equi subsp. Zooepidemicus
Streptococcus equi subsp. Zooepidemicus (SEZ) è un batterio gram positivo β-emolitico appartenente al gruppo C di Lancefield.
Condivide con gli altri appartenenti alla specie Streptococcus equi (S. equi) fino al 98% di sequenze omologhe di DNA (Pelkonen et al., 2013).
SEZ è un patogeno opportunista che può infettare animali domestici e selvatici (Priestnall et al., 2011). In particolare, nel cavallo risulta essere commensale dell’apparato respiratorio e riproduttivo di animali sani. È stato riportato anche nel cane, in cui causa febbre, dispnea, polmonite ed epistassi, e nei casi più gravi può determinare la morte dell’animale. Nei suini e primati sono riportati poliartrite, broncopolmonite, pleurite, pericardite, endocardite e meningite. Nei ruminanti è stato isolato in corso di mastite (Corpa et al., 2018).
Nell’uomo, seppure rara, è documentata la trasmissione determinata dal contatto con equidi infetti, ma sono stati riportati anche casi di infezione in seguito al consumo di latte e prodotti derivati non sottoposti a pastorizzazione (Bordes-Benìtez et al., 2006, Kerdsin et al., 2022). La malattia risulta essere particolarmente severa, caratterizzata da meningite e setticemia.
La conferma della correlazione tra casi clinici avviene mediante estrazione e sequenziamento dell’intero genoma con tecnica Next Generation Sequenzing (NGS), e conseguente determinazione del Multilocus Sequence Typing (MLST) degli isolati batterici, che permette di assegnare i ceppi isolati ad un determinato Sequence Type (ST) (Pelkonen et al., 2013). Sulla base del ST assegnato è possibile correlare i ceppi isolati da soggetti o matrici diverse tra loro. Ancora più discriminante risulta essere l’analisi di mutazioni puntiformi nella sequenza di DNA analizzata, Single Nucleotide Polymorphism (SNP) (EFSA BIOHAZ, 2019).
Il caso: conferma del focolaio, indagine epidemiologica ed isolamento di Streptococcus equi subsp. Zooepidemicus
Tra novembre 2021 e giugno 2022 in provincia di Pescara sono stati notificati un totale di 37 casi associati ad infezione da Streptococcus equi subsp. Zooepidemicus; di questi, cinque sono successivamente deceduti a causa di meningite. La sintomatologia riscontrata ha compreso setticemia, faringite, artrite, uveite ed endocardite. I casi di malattia hanno coinvolto pazienti di età compresa tra 6 e 98 anni e non sono state riportate differenze significative tra i due sessi.
Al fine di gestire l’epidemia sono state coinvolte diverse componenti dell’Autorità Competente (AC), tra i quali il Servizio di Igiene degli alimenti e della Nutrizione (SIAN), i Servizi Veterinari (SSVV) in toto e il Servizio Igiene e Sanità Pubblica (SIESP).
Complessivamente nel corso dell’epidemia sono stati raccolti 21 ceppi isolati da 19 casi clinici, sangue, liquido cefalo-rachidiano e liquido sinoviale. I ceppi sono stati inviati all’Istituto Zooprofilattico Sperimentale dell’Abruzzo e del Molise (IZSAM) per essere identificati mediante analisi di spettrometria di massa (MALDI-TOF) (Bruker Biotyper, Germany) e conferma mediante sequenziamento dell’intero genoma mediante tecnica Next Generation Sequencing (NGS) e analisi del MLST che ha identificato i ceppi in esame come appartenenti al ST61.
La conferma della correlazione tra i ceppi isolati è stata effettuata con analisi SNPs mediante pipeline CFSAN, utilizzando come riferimento il genoma ibrido, ottenuto con tecnologia Illumina e MINION di un ceppo isolato da un caso clinico.
É stata pertanto avviata un’indagine da parte dell’Autorità Competente (AC) volta a identificare la fonte dell’infezione. Nel corso dell’indagine epidemiologica i pazienti hanno riferito il consumo di prodotti lattiero-caseari locali, nella fattispecie prodotti a latte crudo. Le indagini svolte nel territorio hanno permesso di individuare 8 caseifici della zona che producevano prodotti della tipologia indicata.
Pertanto, dopo sopralluogo sono state effettuate due campagne di campionamento. Nel corso della prima sessione sono stati prelevati 9 campioni di latte crudo vaccino e/o ovino, 25 campioni di prodotti lattiero-caseari pastorizzati e non, e 8 campioni di acqua. Tutti i campioni sono stati inviati all’IZSAM per essere esaminati.
Streptococcus equi subsp. Zooepidemicus è stato isolato in un campione di latte di massa bovino prelevato in uno dei caseifici campionati. Successivamente sono stati prelevati campioni nell’unico caseificio risultato positivo al primo prelievo. È stata confermata, così, la presenza nel latte di massa. Inoltre, SEZ è stato isolato anche in formaggi stagionati di 37 e 70 giorni. Il sequenziamento dell'intero genoma ha confermato la similitudine e la correlazione con i ceppi clinici mediante SNP analisi (Figura 1).
Figura 1. Aspetto di Streptococcus equi subsp. Zooepidemicus su piastra Agar Sangue
Conclusione
In conclusione, l’indagine epidemiologica accurata, la tempestività nell’isolamento, l’identificazione dell’agente patogeno, e l’ausilio di tecniche sempre più discriminanti per la caratterizzazione dei ceppi batterici isolati, quali l’NGS, hanno permesso di identificare velocemente la sorgente della contaminazione dei prodotti alimentari, limitando così la trasmissione nell’uomo e garantendo la tutela della salute pubblica. Il coordinamento delle attività tra le parti è stato fondamentale per ottenere questi risultati, che non sarebbero stati possibili senza la collaborazione delle varie componenti delle AC coinvolte.
Il laboratorio dell’IZSAM nello specifico ha svolto attività di supporto all’AC sin dalle fasi iniziali del focolaio, nel mettere a punto un metodo di analisi avente come obiettivo l’isolamento, l’identificazione e la caratterizzazione del microrganismo patogeno, confermando la similitudine tra i ceppi isolati nei casi clinici e quelli isolati negli alimenti, distinguendo i ceppi appartenenti al focolaio e quelli che non ne facevano parte, e ancora oggi continua a fornire supporto all’autorità competente attraverso un’attività di “follow-up” dell’azienda risultata positiva.
Bibliografia
- Bordes-Benítez A, Sánchez-Oñoro M, Suárez-Bordón P, García-Rojas AJ, Saéz-Nieto JA, González-García A, Alamo-Antúnez I, Sánchez-Maroto A, Bolaños-Rivero M. Outbreak of Streptococcus equi subsp. zooepidemicus infections on the island of Gran Canaria associated with the consumption of inadequately pasteurized cheese. Eur J Clin Microbiol Infect Dis. 2006 Apr;25(4):242-6
- Corpa JM, Carvallo F, Anderson ML, Nyaoke AC, Moore JD, Uzal FA. Streptococcus equi subspecies zooepidemicus septicemia in alpacas: three cases and review of the literature. J Vet Diagn Invest. 2018 Jul;30(4):598-602
- EFSA BIOHAZ Panel (EFSA Panel on Biological Hazards), Koutsoumanis, K, Allende, A, Alvarez-Ordóñez, A, Bolton, D, Bover-Cid, S, Chemaly, M, Davies, R, De Cesare, A, Hilbert, F, Lindqvist, R, Nauta, M, Peixe, L, Ru, G, Simmons, M, Skandamis, P, Suffredini, E, Jenkins, C, Malorny, B, Ribeiro Duarte, AS, Torpdahl, M, da Silva Felício, MT, Guerra, B, Rossi, M and Herman, L, 2019. Scientific Opinion on the whole genome sequencing and metagenomics for outbreak investigation, source attribution and risk assessment of food-borne microorganisms. EFSA Journal 2019;17(12):5898, 78 pp.
- Kerdsin, A., Chopjitt, P., Hatrongjit, R., Boueroy, P., & Gottschalk, M. (2022). Zoonotic infection and clonal dissemination of Streptococcus equi subspecies zooepidemicus sequence type 194 isolated from humans in Thailand. Transboundary and Emerging Diseases. 69, e554– e565
- Pelkonen S, Lindahl SB, Suomala P, Karhukorpi J, Vuorinen S, Koivula I, Väisänen T, Pentikäinen J, Autio T, Tuuminen T. Transmission of Streptococcus equi subspecies zooepidemicus infection from horses to humans. Emerg Infect Dis. 2013 Jul;19(7):1041-8
- Priestnall S, Erles K. Streptococcus zooepidemicus: an emerging canine pathogen. Vet J. 2011 May;188(2):142-8. doi: 10.1016/j.tvjl.2010.04.028. Epub 2010 May 31.
De Angelis Maria Elisabetta, Bosica Serena
Istituto Zooprofilattico Sperimentale dell’Abruzzo e del Molise “G. Caporale”
Reparto di Igiene e Tecnologie degli Alimenti